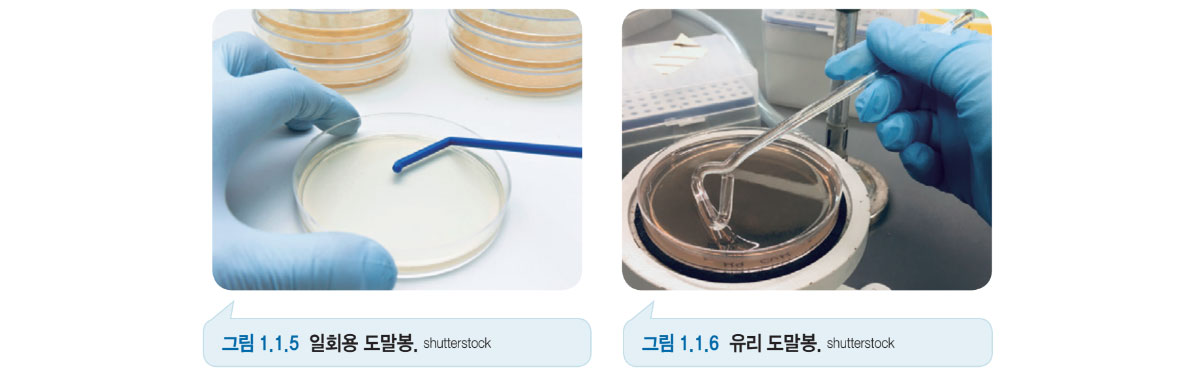

미생물 실험기기 및 기구
1. 마이크로피펫(micropipette)
마이크로피펫은 마이크로리터 단위의 적은 양의 액체를 정확하게 분주하기 위한 실험기구로, 피펫의 끝부분에 필요한 용량의 피펫 팁을 장착하여 사용한다. 이때 사용하는 피펫 팁은 실험 전에 고압멸균기를 이용하여 멸균한 후 사용한다. 측정하는 부피에 따라 사용하는 마이크로피펫의 종류가 다르다. 종류에 따라 눈금의 단위도 달라진다.
2. 백금이와 백금선
금속 재질인 백금이와 백금선의 경우 실험 전후로 충분한 화염멸균이 되어야 한다. 이밖에도 백금이와 백금선이 일체화된 플라스틱 재질의 일회용 제품이 있으며, 멸균 상태로 포장되어 있어 사용할 때는 사용할 부분의 반대편을 개봉하여 사용한다. 백금선은 주로 고체 배지에서 미생물을 채취하거나 미생물을 배지에 접종할 때 사용한다. 백금이는 백금선의 끝을 원형으로 구부린 형태의 기구로 액체 및 고체 배지에서 미생물을 채취할 때 사용한다.
3. 도말봉
주로 액체 상태의 미생물을 고체 배지의 표면에 잘 스며들도록 골고루 도말할 때 사용한다. 금속이나 유리 재질의 도말봉은 실험 전후로 충분히 화염 멸균하여 사용한다.
4. 화염 멸균기
화염 멸균은 가장 신속하고 간단한 멸균 방법으로, 멸균할 물체를 직접 불꽃에 접촉시켜 미생물을 제거한다. 멸균 도구로는 알코올램프, 가스버너 등을 사용하며, 열에 의해 변형되지 않는 금속 기구, 유리 기구 등을 멸균할 때 사용한다. 금속 재질의 백금이, 백금선은 수 초 이내에 빨갛게 달구어진다. 충분히 식힌 후 목적에 맞게 사용한다.
5. 건열 멸균기
건열 멸균은 건조한 고온을 이용하여 미생물을 제거하는 방법이다. 열에 의해 변형되지 않는 금속 기구, 유리 기구를 멸균할 때 사용한다. 건열 멸균기는 160~180°C로 2시간 처리하여 미생물 및 포자까지 완전히 멸균한다. 고압증기 멸균 방식에 비해 멸균 속도가 느리다는 단점이 있지만, 습기에 약한 제품을 멸균할 수 있는 장점이 있다.
6. 고압증기멸균기
고압을 이용하여 미생물을 제거하는 방법이다. 열에 의해 변형되지 않는 금속 기구, 유리 기구의 멸균뿐 아니라 각종 배지, 의류 등의 멸균에도 사용한다. 121°C에서 15~20분간 또는 134°C에서 7분간 멸균하여 미생물 및 포자까지 완전히 멸균한다. 건열 멸균 방식에 비해 멸균 속도가 빠르다는 장점이 있다.
7. 무균작업대(Clean bench)
무균작업대는 외부 환경과 격리된 공간을 제공함으로써 무균 실험을 할 수 있는 작업대이다. 헤파 필터(HEPA filter)를 거친 외부 공기가 무균작업대 내부로 불어넣어지고, 공기의 흐름이 생겨 외부 미생물이 들어갈 수 없도록 한다. 실험하지 않을 때는 자외선 살균 등을 켜놓아 작업대 내부를 살균하게 된다.